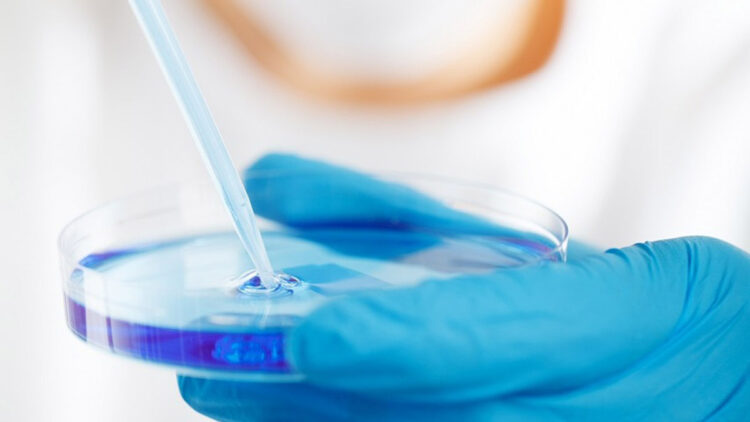
Yapay zekayla yeni bir antibiyotik bulundu

ABD’li ve Kanadalı bilim insanları, yapay zeka kullanarak ölümcül ve ilaca dirençli bakteri için yeni bir antibiyotik keşfettiklerini açıkladı.
Kanada merkezli McMaster Üniversitesi ile ABD merkezli Massachusetts Teknoloji Enstitüsü’nden (MIT) bilim insanları, dün yapay zeka kullanarak Dünya Sağlık Örgütü’nün (DSÖ) dünyanın en tehlikeli, antibiyotiğe dirençli bakterilerinden biri olarak tanımladığı Acinetobacter baumannii’ye karşı antibiyotik keşfettiklerini açıkladı.
Genellikle hastanelerde bulunan ve yüzeylerde uzun süre yaşayan bakterinin zatürree, menenjit ve yaraları enfekte ederek ölüme yol açtığını belirten bilim insanları, yapay zekanın zaman alan araştırma süreçlerini büyük oranda kısalttığını ifade etti.
DİĞER BAKTERİLERDEN DNA TOPLAYIP GÜÇLENİYOR
Acinetobacter baumannii bakterisi, antibiyotiğe dirençli genler de dahil olmak üzere ortamdaki diğer bakteri türlerinden DNA toplayarak dirençli hale geliyor. Ancak bilim insanları, antibakteriyel moleküllerin yeni yapısal sınıflarını tahmin etmek için bir yapay zeka algoritması kullandı ve Abaucin adını verdikleri yeni bir antibakteriyel bileşik keşfetti.
Araştırmacılar Abaucin’in özellikle ümit verici olduğunu, çünkü yalnızca A. baumannii’yi hedef aldığını ve bakterinin hızla ilaç direnci geliştirme olasılığını düşürerek daha kesin ve etkili tedaviler sunduğunu ifade etti.